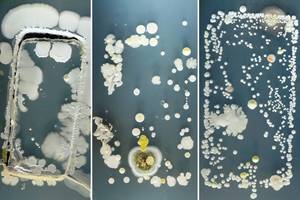
Pamatykite, kokios bakterijų civilizacijos veisiasi ant telefonų

Tyrimo rezultatai rodo, kad šis įprotis yra ne tik nehigieniškas, bet ir gali gerokai padidinti hemorojaus – aplink tiesiąją žarną ir išangę esančių kraujagyslių išsiplėtimų, kurie gali sukelti skausmą ir kraujavimą – riziką.
JAV mokslininkai atliko 125 suaugusiųjų, kurių žarnyno sveikata buvo tiriama atliekant kolonoskopiją (procedūra, kurios metu gydytojai į žarnyną įveda kamerą), apklausą.
Dalyviai atsakinėjo į klausimus apie savo gyvenimo būdą ir tuštinimosi įpročius, o kolonoskopiją atlikę gydytojai įvertino, ar jie neturi hemorojaus.
Susiję straipsniai
Iš viso 66 proc. dalyvių teigė, kad tuštindamiesi naudojasi išmaniuoju telefonu – ir dažniausiai naršo socialiniuose tinkluose arba skaito naujienas. Jaunesni dalyviai dažniau naršė telefonu sėdėdami ant tualeto nei vyresni.
Tyrėjai, atlikdami statistinę analizę, atsižvelgė į kitus su hemorojaus rizika susijusius veiksnius, tokius kaip fizinis aktyvumas, amžius ir mityba.
Rezultatai parodė, kad asmenys, kurie naudojasi telefonu besituštindami, turi 46 proc. didesnę hemorojaus riziką nei tie, kurie to nedaro.
Kodėl naršymas tualete toks žalingas? Viskas priklauso nuo to, kiek laiko sėdite ant tualeto – o šis laikas gali pailgėti, kai esate įsitraukę į telefoną.
Net 37 proc. šio tyrimo dalyvių, kurie naršo tualete, prisipažino, kad tualete įprastai praleidžia daugiau nei penkias minutes – tiek laiko tualete praleidžia tik 7,1 proc. nenaršančių.
Mokslininkai padarė prielaidą, kad šis papildomas laikas gali padidinti spaudimą apatinei kūno daliai, įskaitant išangės audinius, kurie gali nulemti hemorojaus atsiradimą.
Vyresnioji tyrimo autorė, Harvardo universiteto medicinos profesorė dr. Trisha Pasricha patarė nesinešti išmaniojo telefono į tualetą. „Jis atitraukia jūsų dėmesį nuo atliekamos užduoties“, – sakė ji.
Nors iki šiol buvo teiginių, siejančių hemorojų su telefono naudojimu tualete, stebėtinai nedaug tyrimų tai patvirtino.
„Manau, kad mums dar daug reikia sužinoti apie nuolatinio naršymo telefone poveikį sveikatai, – sakė T. Pasricha. – Mūsų tyrimas parodė ryšį tarp naudojimosi išmaniuoju telefonu tualete ir hemorojaus, tačiau tai tik pirmas žingsnis. Tikiuosi, kad šioje srityje bus atlikta daug daugiau tyrimų.“
Parengta pagal „BBC Science Focus“.